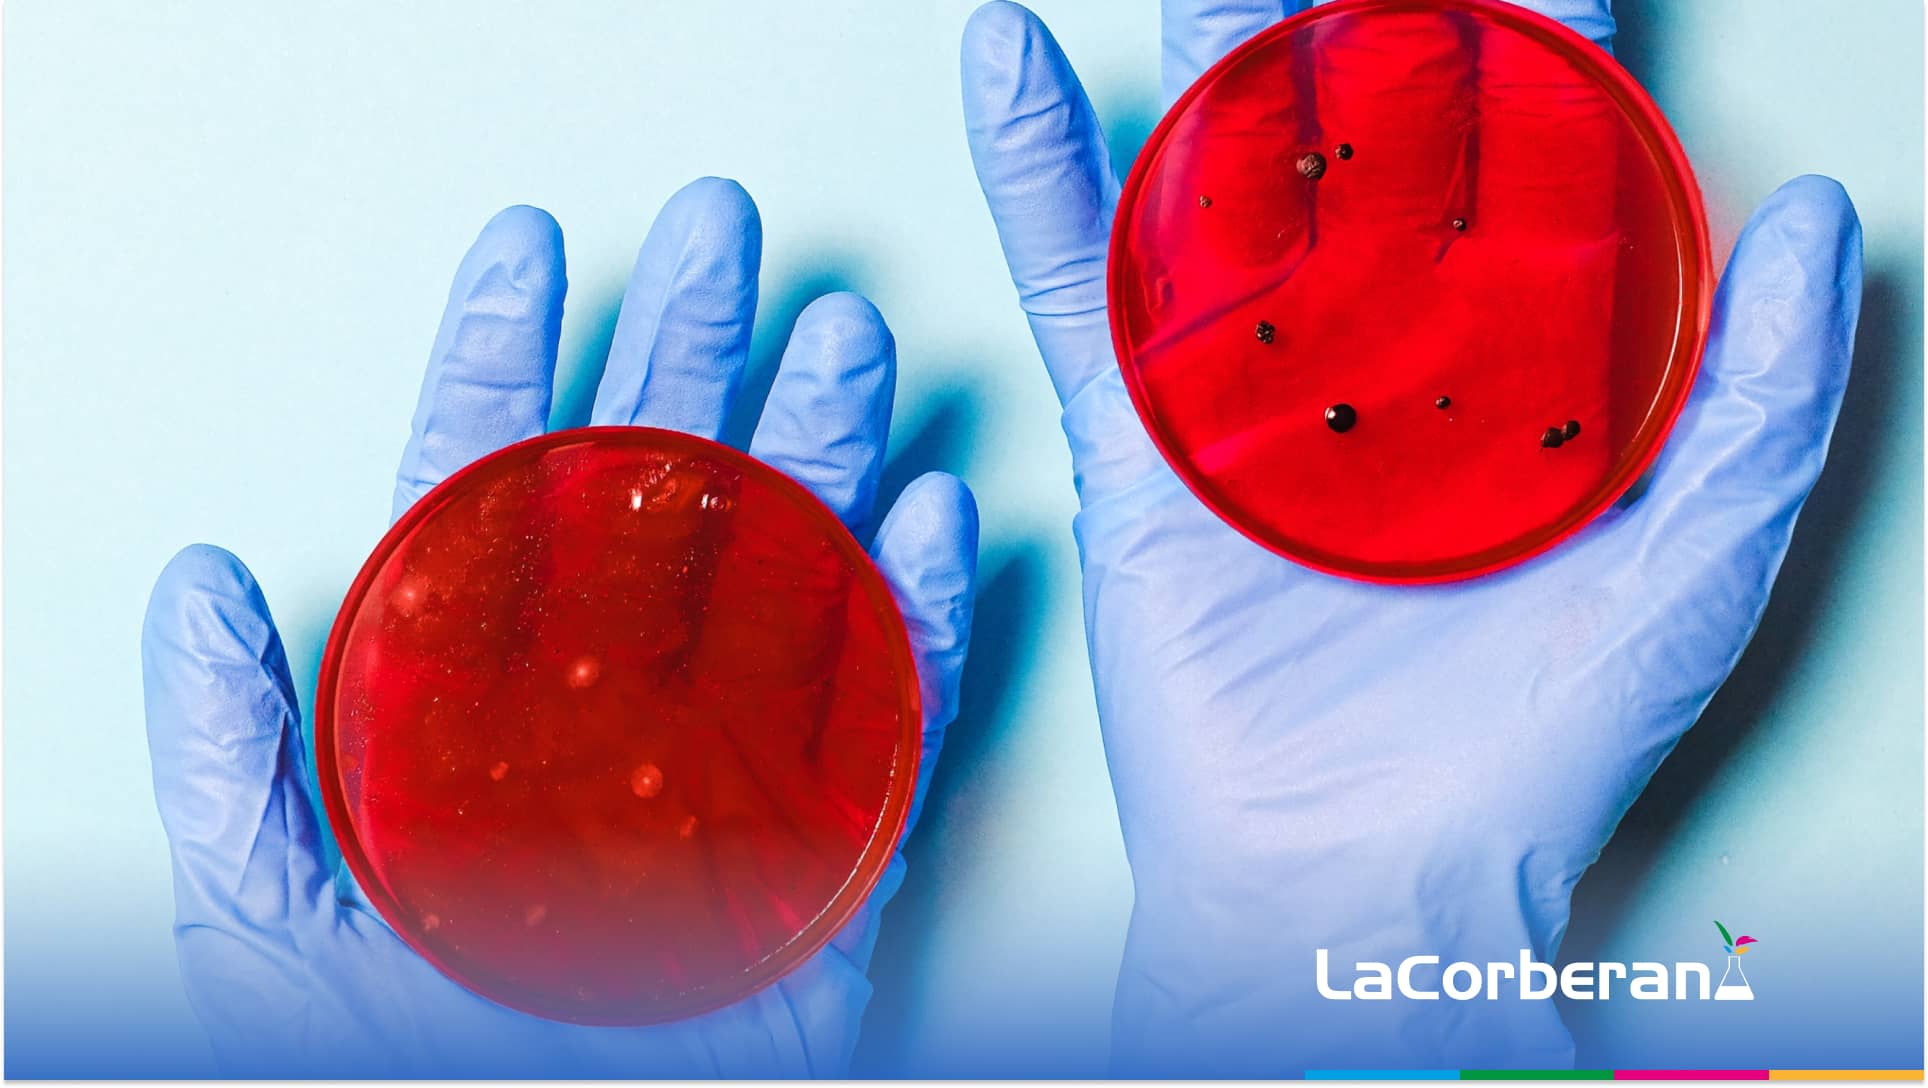

In this article we are going to see the difference between bactericides and bacteriostatics , what each of them is used for, and why they are so important in cleaning, and the fact is that cleanliness and hygiene in the workplace is one of the fundamental factors for the good running of a company. Not only does it impact the image projected by the business, it also facilitates and improves the working conditions of employees.
It is also key to achieving the optimal environment for the development of your activity, especially if it is related to direct contact with the client.
To achieve perfect cleaning and hygiene, it is necessary to use professional products designed to achieve different cleaning objectives.
The products bactericidal and bacteriostatic They are, without a doubt, a non-negotiable resource to guarantee the perfect disinfection of a work environment .
What is a bactericidal product? And a bacteriostatic product? Are they the same thing? Keep reading, we will tell you everything you need to know about these two important professional cleaning products. Take note!
What is a bactericide
A bactericidal product It is one that is composed of substances that They eliminate or kill bacteria . These substances have an inhibitory effect on the bacteria's enzymes, which are key to their life.
Let us remember that bacteria are organisms that can live in different conditions, both cold and hot, and in some cases, can cause harm to humans and animals.
Their strong resistance is one of their qualities that makes them difficult to eliminate, which is why it is necessary to apply bactericidal products capable of eliminating them.
These bactericidal products can be disinfectants , antiseptics or antibiotics .
Importance of bactericides in cleaning
A good cleaning is always based on a correct disinfection, therefore, the Professional bactericidal products occupy a primary place in professional cleaning. from any work or home environment.
The Importance of bactericides in cleaning It is essential because they are the only resource that guarantees the total elimination of bacteria on a surface .
The The presence of bacteria on surfaces can pose a health risk , as they can transmit diseases and contaminate the products being handled. In addition, bacteria can proliferate rapidly under favorable conditions, such as the presence of moisture and nutrients, which can result in widespread contamination.
Related content:
- Flocculant. What it is, what it is used for and how to use it
- Hydrochloric acid for pool water treatment
- Cleaning and Disinfection in the Food Industry
What is a bacteriostatic
A Bacteriostatic product is designed to inhibit the growth and multiplication of bacterial cells , rather than killing them directly.
Bacteriostatic substances obstruct the metabolic mechanisms of the bacterial cell, in most cases targeting protein synthesis.
Importance of bacteriostatics in cleaning
The Bacteriostatics are important in professional cleaning because they are substances that inhibit the growth of bacteria on the surfaces where they are applied. This is especially important in environments where hygiene is critical, such as hospitals, clinics, laboratories and other places where food products are handled.
The Bacteriostatics can help prevent the spread of disease and keep environments clean and safe. By inhibiting the growth of bacteria, they reduce the possibility of contamination and minimize the risk of infections.
In short, the Bacteriostatics are important in professional cleaning because they help ensure safety and hygiene in critical environments. and reduce the risk of disease and contamination.
Differences between a bactericide and a bacteriostatic
At this point we must emphasize the substantial differences between a bactericidal product and a bacteriostatic one.
Bactericidal products kill bacteria. Bacteriostatic products, on the other hand, prevent the growth and spread of bacteria.
Both products have one thing in common: preventing the growth and reproduction of bacteria.
When to use each one
Both products are important for proper cleaning . Bactericides are much more aggressive products and are focused on eliminating bacteria in situations of heavy dirtiness, thus eliminating the problem.
Bacteriostatic products offer a less aggressive cleaning but help to disinfect the area, preventing the growth of bacteria.
Both are recommended for cleaning particularly delicate areas, such as in the healthcare sector or the food industry, among others.
Best bactericidal cleaning products
There is a wide catalogue of bactericidal products, among others, we can recommend the following highly recommended bactericidal products for cleaning:
- LC CLOR HA . It is a chlorinated bactericidal and fungicidal product. The product LC CHLOR HA It is ideal for disinfecting surfaces and food facilities.
- VIRTUOSO . The disinfectant and degreaser VIRTUOUS Complies with UNE 13697 and UNE-EN 14476. Suitable for environmental use and the food industry.
- PULCRO_C19 . A good Hydroalcoholic disinfectant like the product PULRO_C19 It is effective for disinfecting surfaces and in any environment that requires high hygienic quality.
- CORCIDE-LC . Broad spectrum disinfectants such as the product CORCIDE-LC They guarantee perfect disinfection of surfaces and work environments.
Bactericidal and bacteriostatic products are a fundamental resource to guarantee an effective cleaning process with high quality results.
 Skip to content
Skip to content